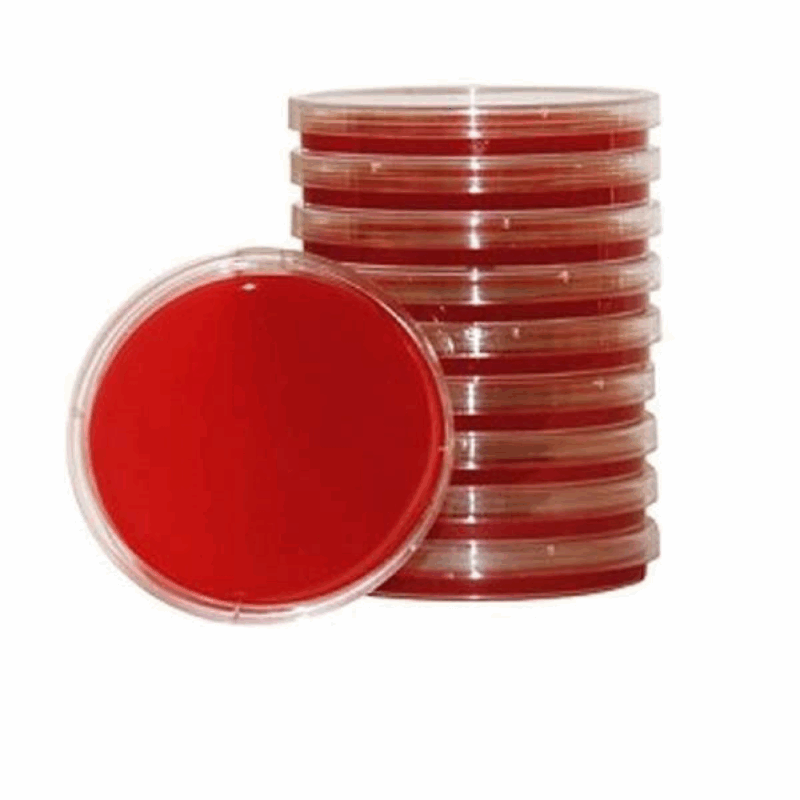
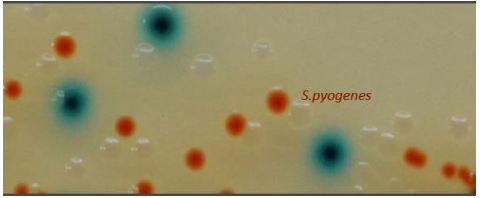

- Δίσκοι ευαισθησίας
- Προϊόντα ταυτοποίησης
- Χρωστικές
- Αναλώσιμα εργαστηρίου
- Αναλώσιμα αναλυτών
- Σωληνάρια αιμοληψιών
- Σωληνάρια αιμοληψιών κενού
- Σωληνάρια πλαστικά – πώματα
- Σύριγγες – βελόνες – πεταλούδες
- Αντικειμενοφόρες πλάκες – καλυπτρίδες – μικροαιματοκρίτες
- Πιπέτες Pasteur
- Πιπέτες Καθίζησης – Στατώ Καθίζησης
- Ρύγχη
- Τρυβλία
- Στυλεοί – κρικοφόροι
- Διαλύματα γλυκόζης
- Λάστιχο αιμοληψίας
- Παραφίλμ
- Strips
- Βαμβάκι
- Δοχεία απόρριψης βελονών
- Ουροδοχεία
- Θρεπτικά Υλικά
- Διάφορα αντιδραστήρια

Μικροβιολογικά
Αναζητείστε πιστοποιημένα ποιοτικά προϊόντα ιατρικών μικροβιολογικών αναλωσίμων και εξοπλισμό υψηλής
ποιότητας και τεχνολογίας από το e-shop της εταιρείας BELEKOUKIAS Medical Supplies σε τιμές που αγγίζουν την
χονδρική.

Νοσοκομειακά - Γενική Ιατρική
Η εταιρεία BELEKOUKIAS Medical Supplies προτείνει νοσοκομειακά και γενικής ιατρικής αναλώσιμα είδη που καλύπτουν ιδανικά κάθε άμεση ανάγκη για Νοσοκομεία – κλινικές , Ιατρικούς χώρους , Αισθητικής & Δερματολόγους , home care.

Οδοντιατρικά
Στο e-shop της εταιρείας BELEKOUKIAS Medical supplies παρουσιάζουμε μια ολοκληρωμένη σειρά οδοντιατρικών προϊόντων μιας χρήσης καθώς και τοπικών οδοντιατρικών αναισθητικών και βελονών ενδοδοντίας.

Καρδιολογικά
Ανακαλύψτε αναλώσιμα καρδιολογικά είδη και αποκτήστε τον απαραίτητο αλλά και τον πιο αξιόπιστο εξοπλισμό για το ιατρείο σας από τη εταιρεία BELEKOUKIAS Medical Supplies.
Η ποικιλία σε καρδιολογικά αναλώσιμα περιλαμβάνει πουάρ καρδιογράφου, ζελέ, ηλεκτρόδια, μανταλάκια, χαρτί καρδιογράφου κ.λπ.
Βρείτε τα σε οικονομικές τιμές από το e-shop της εταιρείας BELEKOUKIAS Medical Supplies

Φυσικοθεραπείας
Η εταιρεία BELEKOUKIAS Medical Supplies πρόσφατα μπήκε στο τομέα της φυσικοθεραπείας εμπλουτίζοντας το πορτφόλιο με νέα προϊόντα σε αναλώσιμο υλικό και σε εξοπλισμό.
Ο κατάλογος σε προϊόντα για τους υσικοθεραπευτές περιλαμβάνει ηλεκτρόδια, ζελέ, αντάπτορες, ιμάντες ηλεκτροδίων, καθώς και συσκευές υπερήχων, φορητά κρεβάτια κ.α.

Γυναικολογικά
Στο e-shop της εταιρείας BELEKOUKIAS Medical supplies θα σας καλύψουμε με υψηλής ποιότητας γυναικολογικά αναλώσιμα για αξιόπιστη εξέταση και διάγνωση.

Αθλητιατρικά ορθωτικά ZAMST
Ο πραγματικός ηγέτης στην τεχνολογία των αθλητιατρικών προϊόντων και την πρόληψη των τραυματισμών στο e-shop της εταιρείας BELEKOUKIAS Medical Supplies.
Η Zamst ενισχύει και προστατεύει τους αθλητές παρέχοντας τεχνικά προϊόντα υψηλής ποιότητας που προέρχονται από καινοτόμα υλικά, σχέδια και διαδικασίες κατασκευής.

Επιδεσμικό υλικό
Η εταιρεία BELEKOUKIAS Medical Supplies παρέχει μέσω του e-shop σειρά επιδεσμικού υλικού με άριστη σχέση ποιότητας-τιμής για την φροντίδα των τραυμάτων.
ΚΑΤΗΓΟΡΙΕΣ
ΠΡΟΙΟΝΤΑ
BLOOD AGAR (HORSE BLOOD) BIOPREPARE Τρυβλίο 90 mm
Ένα υλικό που συνιστάται για την καλλιέργεια μιας μεγάλης ποικιλίας παθογόνων μικροοργανισμών. Τo υλικό αυτό παρασκευάζεται με την προσθήκη 5% αίματος αλόγου.
ℹ️ Ελάχιστη Παραγγελία: 10 x 90 mm ℹ️ Συσκευασία: 10 x 90 mm
⚠️Οι τελικές τιμές επιβεβαιώνονται με την λήψη του προτιμολογίου και ενδέχεται να αλλάξουν χωρίς ειδοποίηση. ⚠️Οι φωτογραφίες έχουν αποκλειστικά ενδεικτικό χαρακτήρα & ενδέχεται να διαφέρoυν από το πραγματικό προϊόν.
BLOOD AGAR BASE BIOPREPARE Φιαλίδιο 100 ml
Το BLOOD AGAR BASE ένα υλικό που συνιστάται για την καλλιέργεια μιας μεγάλης ποικιλίας παθογόνων μικροοργανισμών. Τα υλικά αυτά συνήθως παρασκευάζονται με την προσθήκη 5 - 10% αίματος.
ℹ️ ΧΡΟΝΟΣ ΖΩΗΣ: 365 ημέρες ℹ️ ΦΥΛΑΞΗ : 2 – 25* C
ℹ️ Ελάχιστη Παραγγελία: 10 x 100 ml ℹ️ Συσκευασία: 10 x 100 ml
⚠️Οι τελικές τιμές επιβεβαιώνονται με την λήψη του προτιμολογίου και ενδέχεται να αλλάξουν χωρίς ειδοποίηση. ⚠️Οι φωτογραφίες έχουν αποκλειστικά ενδεικτικό χαρακτήρα & ενδέχεται να διαφέρoυν από το πραγματικό προϊόν.
BLOOD AGAR–MAC CONKEY AGAR No2 BIOPREPARE Διχοτομημένο Τρυβλίο 90 mm
Διχοτομημένο τρυβλίο BLOOD AGAR – MAC CONKEY AGAR No2 για την καλλιέργεια όλων των αερόβιων βακτηρίων και ταυτοποίηση των αιμολυτικών gram(+) κόκκων (BLOOD AGAR). – Για την καλλιέργεια , απομόνωση και ταυτοποίηση των εντεροβακτηριδίων και του εντερόκοκκου (MAC CONKEY AGAR No2).
ℹ️ Ελάχιστη Παραγγελία: 10 x 90 mm ℹ️ Συσκευασία: 10 x 90 mm
ℹ️ ΧΡΟΝΟΣ ΖΩΗΣ: 60 ημέρες ℹ️ ΦΥΛΑΞΗ : 2 – 8* C
⚠️Οι τελικές τιμές επιβεβαιώνονται με την λήψη του προτιμολογίου και ενδέχεται να αλλάξουν χωρίς ειδοποίηση. ⚠️Οι φωτογραφίες έχουν αποκλειστικά ενδεικτικό χαρακτήρα & ενδέχεται να διαφέρoυν από το πραγματικό προϊόν.
CHROMagar Strep A BIOPREPARE Τρυβλίο 90 mm
Το CHROMagar™ Strep Α χρησιμοποιείται για τη Ταυτοποίηση Στρεπτόκοκκων της ομάδας Α (Streptococcus pyogenes) στα φαρυγγικά δείγματα.
ℹ️ Ελάχιστη Παραγγελία: 10 x 90 mm ℹ️ Συσκευασία: 10 x 90 mm
⚠️Οι τελικές τιμές επιβεβαιώνονται με την λήψη του προτιμολογίου και ενδέχεται να αλλάξουν χωρίς ειδοποίηση. ⚠️Οι φωτογραφίες έχουν αποκλειστικά ενδεικτικό χαρακτήρα & ενδέχεται να διαφέρoυν από το πραγματικό προϊόν.
CHROMagar Strep B BIOPREPARE Τρυβλίο 90 mm
Το CHROMagar™ Strep B χρησιμοποιείται για τη χρωματική διαφοροποίηση Streptococcus agalactiae (GBS) από το χρώμα της αποικίας.
ℹ️ Ελάχιστη Παραγγελία: 10 x 90 mm ℹ️ Συσκευασία: 10 x 90 mm
⚠️Οι τελικές τιμές επιβεβαιώνονται με την λήψη του προτιμολογίου και ενδέχεται να αλλάξουν χωρίς ειδοποίηση. ⚠️Οι φωτογραφίες έχουν αποκλειστικά ενδεικτικό χαρακτήρα & ενδέχεται να διαφέρoυν από το πραγματικό προϊόν.
Cleanisept – 1000ml
ΦΥΣΙΚΟΘΕΡΑΠΕΙΑ, Απολύμανση - Αντισηψία, ΚΑΡΔΙΟΛΟΓΙΚΑ, Απολύμανση - Αντισηψία, ΓΥΝΑΙΚΟΛΟΓΙΚΑ, Απολύμανση – Αντισηψία, ΝΟΣΟΚΟΜΕΙΑΚΑ ΕΙΔΗ, Απολύμανση-Αντισηψία
Το Cleanisept είναι ένα συμπυκνωμένο άοσμο διάλυμα, χωρίς αιθανόλη, αλδεΰδες και φαινόλες, το οποίο μπορεί να χρησιμοποιηθεί σε καθημερινή βάση για την απολύμανση και τον καθαρισμό των δαπέδων και των επιφανειών. Μπορεί να χρησιμοποιηθεί σαν διάλυμα ταχείας απολύμανσης για επιφάνειες από ακρυλικό γυαλί.Είναι ιδανικό για χώρους εστίασης, καθώς επίσης και για χώρους αναμονής, ιατρεία κτλ.
Συμβουλευτείτε τις οδηγίες για να επιτύχετε τη σωστή αραίωση σύμφωνα με την επιθυμητή χρήση.
Περιεχόμενο: 1000ml Τεμάχια συσκευασίας: 1
⚠️Οι τελικές τιμές επιβεβαιώνονται με την λήψη του προτιμολογίου και ενδέχεται να αλλάξουν χωρίς ειδοποίηση. ⚠️Οι φωτογραφίες έχουν αποκλειστικά ενδεικτικό χαρακτήρα & ενδέχεται να διαφέρoυν από το πραγματικό προϊόν.
Cleanisept – 5000ml
ΦΥΣΙΚΟΘΕΡΑΠΕΙΑ, Απολύμανση - Αντισηψία, ΚΑΡΔΙΟΛΟΓΙΚΑ, Απολύμανση - Αντισηψία, ΓΥΝΑΙΚΟΛΟΓΙΚΑ, Απολύμανση – Αντισηψία, ΝΟΣΟΚΟΜΕΙΑΚΑ ΕΙΔΗ, Απολύμανση-Αντισηψία
Το Cleanisept είναι ένα συμπυκνωμένο άοσμο διάλυμα, χωρίς αιθανόλη, αλδεΰδες και φαινόλες, το οποίο μπορεί να χρησιμοποιηθεί σε καθημερινή βάση για την απολύμανση και τον καθαρισμό των δαπέδων και των επιφανειών. Μπορεί να χρησιμοποιηθεί σαν διάλυμα ταχείας απολύμανσης για επιφάνειες από ακρυλικό γυαλί.Είναι ιδανικό για χώρους εστίασης, καθώς επίσης και για χώρους αναμονής, ιατρεία κτλ.
Συμβουλευτείτε τις οδηγίες για να επιτύχετε τη σωστή αραίωση σύμφωνα με την επιθυμητή χρήση.
Περιεχόμενο: 5000ml Τεμάχια συσκευασίας: 1
⚠️Οι τελικές τιμές επιβεβαιώνονται με την λήψη του προτιμολογίου και ενδέχεται να αλλάξουν χωρίς ειδοποίηση. ⚠️Οι φωτογραφίες έχουν αποκλειστικά ενδεικτικό χαρακτήρα & ενδέχεται να διαφέρoυν από το πραγματικό προϊόν.
Cleanisept Wipes 14x20cm Dr. Schumacher GmbH
ΦΥΣΙΚΟΘΕΡΑΠΕΙΑ, Απολύμανση - Αντισηψία, ΚΑΡΔΙΟΛΟΓΙΚΑ, Απολύμανση - Αντισηψία, ΓΥΝΑΙΚΟΛΟΓΙΚΑ, Απολύμανση – Αντισηψία, ΝΟΣΟΚΟΜΕΙΑΚΑ ΕΙΔΗ, Απολύμανση-Αντισηψία
Τα Cleanisept wipes είναι μαντηλάκια έτοιμα προς χρήση, για την ταχεία απολύμανση και τον καθαρισμό των ιατρικών συσκευών και των περιοχών που βρίσκονται κοντά στον ασθενή.
Είναι ιδιαίτερα κατάλληλα για ιατρικές συσκευές που είναι ευαίσθητες στο αλκοόλ, όπως ανιχνευτές υπερήχων που δεν πρέπει να έρθουν σε επαφή με τους βλεννογόνους.
Διαστάσεις: 14cm x 20cm Τεμάχια συσκευασίας: 1 x 100 τμχ.
⚠️Οι τελικές τιμές επιβεβαιώνονται με την λήψη του προτιμολογίου και ενδέχεται να αλλάξουν χωρίς ειδοποίηση. ⚠️Οι φωτογραφίες έχουν αποκλειστικά ενδεικτικό χαρακτήρα & ενδέχεται να διαφέρoυν από το πραγματικό προϊόν.
Cleanisept Wipes Forte Ταχεία Απολύμανση 14Χ20cm
ΦΥΣΙΚΟΘΕΡΑΠΕΙΑ, Απολύμανση - Αντισηψία, ΚΑΡΔΙΟΛΟΓΙΚΑ, Απολύμανση - Αντισηψία, ΓΥΝΑΙΚΟΛΟΓΙΚΑ, Απολύμανση – Αντισηψία, ΝΟΣΟΚΟΜΕΙΑΚΑ ΕΙΔΗ, Απολύμανση-Αντισηψία
Έτοιμα προς χρήση μαντηλάκια απολύμανσης χωρίς αλκοόλ, ιοκτόνα και σποριοκτόνα για την ταχεία απολύμανση μικρών επιφανειών.
Τα Cleanisept Wipes Forte μπορούν να αφαιρεθούν εύκολα από το κουτί, ξεχωριστά και γρήγορα ώστε να είναι έτοιμα για χρήση.
Το υγρό απολυμαντικό είναι χωρίς αλκοόλ και χωρίς αλδεΰδες ή φαινόλες. Είναι ιδανικά για ανιχνευτές υπερήχων που έρχονται σε επαφή με τους βλεννογόνους.
Διαστάσεις: 14cm x 20cm Τεμάχια συσκευασίας: 1 x 100 τμχ.
⚠️Οι τελικές τιμές επιβεβαιώνονται με την λήψη του προτιμολογίου και ενδέχεται να αλλάξουν χωρίς ειδοποίηση. ⚠️Οι φωτογραφίες έχουν αποκλειστικά ενδεικτικό χαρακτήρα & ενδέχεται να διαφέρoυν από το πραγματικό προϊόν.
CRYSTAL VIOLET SOLUTION 250ml Deltalab
Η ΕΤΑΙΡΕΙΑ ΜΑΣ
Η εταιρεία μας είναι μια σύγχρονη πιστοποιημένη ελληνική εταιρεία που δραστηροποιείται στους κλάδους της Υγείας και βιο-ιατρικής έρευνας τους οποίους υπηρετεί με συνέπεια και ευθύνη, διαθέτοντας υψηλής ποιότητας και τεχνολογίας προιόντα ιατρικού αναλώσιμου υλικού και εξοπλισμό υψηλής ποιότητας και τεχνολογίας για τον ιδιωτικό τομέα.

ΝΕΑ ΠΡΟΙΟΝΤΑ
CHROMagar Strep A BIOPREPARE Τρυβλίο 90 mm
Το CHROMagar™ Strep Α χρησιμοποιείται για τη Ταυτοποίηση Στρεπτόκοκκων της ομάδας Α (Streptococcus pyogenes) στα φαρυγγικά δείγματα.
ℹ️ Ελάχιστη Παραγγελία: 10 x 90 mm ℹ️ Συσκευασία: 10 x 90 mm
⚠️Οι τελικές τιμές επιβεβαιώνονται με την λήψη του προτιμολογίου και ενδέχεται να αλλάξουν χωρίς ειδοποίηση. ⚠️Οι φωτογραφίες έχουν αποκλειστικά ενδεικτικό χαρακτήρα & ενδέχεται να διαφέρoυν από το πραγματικό προϊόν.
BLOOD AGAR–MAC CONKEY AGAR No2 BIOPREPARE Διχοτομημένο Τρυβλίο 90 mm
Διχοτομημένο τρυβλίο BLOOD AGAR – MAC CONKEY AGAR No2 για την καλλιέργεια όλων των αερόβιων βακτηρίων και ταυτοποίηση των αιμολυτικών gram(+) κόκκων (BLOOD AGAR). – Για την καλλιέργεια , απομόνωση και ταυτοποίηση των εντεροβακτηριδίων και του εντερόκοκκου (MAC CONKEY AGAR No2).
ℹ️ Ελάχιστη Παραγγελία: 10 x 90 mm ℹ️ Συσκευασία: 10 x 90 mm
ℹ️ ΧΡΟΝΟΣ ΖΩΗΣ: 60 ημέρες ℹ️ ΦΥΛΑΞΗ : 2 – 8* C
⚠️Οι τελικές τιμές επιβεβαιώνονται με την λήψη του προτιμολογίου και ενδέχεται να αλλάξουν χωρίς ειδοποίηση. ⚠️Οι φωτογραφίες έχουν αποκλειστικά ενδεικτικό χαρακτήρα & ενδέχεται να διαφέρoυν από το πραγματικό προϊόν.
BLOOD AGAR BASE BIOPREPARE Φιαλίδιο 100 ml
Το BLOOD AGAR BASE ένα υλικό που συνιστάται για την καλλιέργεια μιας μεγάλης ποικιλίας παθογόνων μικροοργανισμών. Τα υλικά αυτά συνήθως παρασκευάζονται με την προσθήκη 5 - 10% αίματος.
ℹ️ ΧΡΟΝΟΣ ΖΩΗΣ: 365 ημέρες ℹ️ ΦΥΛΑΞΗ : 2 – 25* C
ℹ️ Ελάχιστη Παραγγελία: 10 x 100 ml ℹ️ Συσκευασία: 10 x 100 ml
⚠️Οι τελικές τιμές επιβεβαιώνονται με την λήψη του προτιμολογίου και ενδέχεται να αλλάξουν χωρίς ειδοποίηση. ⚠️Οι φωτογραφίες έχουν αποκλειστικά ενδεικτικό χαρακτήρα & ενδέχεται να διαφέρoυν από το πραγματικό προϊόν.
MAC CONKEY AGAR No2 BIOPREPARE Φιαλίδιο 100 ml
Για την καλλιέργεια και ταυτοποίηση των εντεροβακτηριδίων και του Εντερόκοκκου.
ℹ️ Ελάχιστη Παραγγελία: 10 x 100 ml ℹ️ Συσκευασία: 10 x 100 ml
⚠️ Οι τελικές τιμές επιβεβαιώνονται με την λήψη του προτιμολογίου και ενδέχεται να αλλάξουν χωρίς ειδοποίηση. ⚠️ Οι φωτογραφίες έχουν αποκλειστικά ενδεικτικό χαρακτήρα & ενδέχεται να διαφέρoυν από το πραγματικό προϊόν.
Σωληνάρια TAPVAL πλαστικά με 3Na Citrate (3,8%), για 1ml αίμα, για ΤΚΕ.
Σωληνάρια πλαστικά με 3Na Citrate (3,8%), διαστάσεων 55Χ12mm, για 1ml αίμα, με μαύρο πώμα εύκολης διάτρησης, για ΤΚΕ.
ℹ️ Ελάχιστη Παραγγελία: 100 τεμάχια. ℹ️ Συσκευασία κιβωτίου: 1000 τεμάχια.
⚠️Οι τελικές τιμές επιβεβαιώνονται με την λήψη του προτιμολογίου και ενδέχεται να αλλάξουν χωρίς ειδοποίηση. ⚠️Οι φωτογραφίες έχουν αποκλειστικά ενδεικτικό χαρακτήρα & ενδέχεται να διαφέρoυν από το πραγματικό προϊόν.
Ρύγχη Πιπετών 100-1000 ul, Τύπου Eppendorf-Brand-Socorex – FL medical (PROMED)
Πιεσόμετρο Μπράτσου Nissei Delicare
Ηλεκτρονικό πιεσόμετρο μπράτσου για μη-εισβολική μέτρηση συστολικής & διαστολικής αρτηριακής πίεσης, τον προσδιορισμό της συχνότητας ή πίεσης των παλμών σε ενήλικες.
• Εγγύηση 5 ετών & service
Κατασκευαστής: Nihon Seimitsu Sokki CO., LTD.
ℹ️ Ελάχιστη Παραγγελία: 1 τεμ. ℹ️ Συσκευασία κιβωτίου: 12 τεμ.
⚠️Οι τελικές τιμές επιβεβαιώνονται με την λήψη του προτιμολογίου και ενδέχεται να αλλάξουν χωρίς ειδοποίηση. ⚠️Οι φωτογραφίες έχουν αποκλειστικά ενδεικτικό χαρακτήρα & ενδέχεται να διαφέρoυν από το πραγματικό προϊόν.
PG473W Ηλεκτρόδια με καλώδιο – 45mm x 80mm
REA TAPE Sport 3.8cm x 10m – Λευκή
Το Rea Tape Sport είναι κατασκευασμένο από 100% βαμβακερό πορώδες υλικό οξειδίου ψευδαργύρου που προσκολλάται, το οποίο είναι μη ελαστικό.Το Rea tape sport έχει σχεδιαστεί για μέγιστη κολλητικότητα. Αυτή η ταινία δεν είναι σαν τις υπόλοιπες μάρκες που υπάρχουν στην αγορά.Το Rea tape sport ξετυλίγεται ομαλά και σταθερά μέχρι τον πυρήνα και σκίζεται εύκολα με το χέρι, ώστε να μην χρειάζεται να κόβετε με το ψαλίδι.
Οποιοσδήποτε αθλητικός προπονητής θα μπορεί να νιώσει τη διαφορά στην ποιότητα μόλις αρχίσει να το χρησιμοποιεί.
ℹ️ Ελάχιστη παραγγελία: 32 τεμάχια
MYCOTEST M. hominis (M.h.) και U. urealyticum (U.u.) BIOPREPARE 2 x 1,2ml 10 test
Το Mycotest χρησιμοποιείται για την ταυτοποίηση και τον ημιποσοτικό προσδιορισμό των ουρογεννητικών μυκοπλασμάτων M. hominis (Mh) και U. urealyticum (Uu).
ℹ️ Συσκευασία: 10 σωληνάρια (2 x 1,2 ml)
⚠️Οι τελικές τιμές επιβεβαιώνονται με την λήψη του προτιμολογίου και ενδέχεται να αλλάξουν χωρίς ειδοποίηση. ⚠️Οι φωτογραφίες έχουν αποκλειστικά ενδεικτικό χαρακτήρα & ενδέχεται να διαφέρoυν από το πραγματικό προϊόν.
Στατώ σωληναρίων πλαστικά, από ABS, Ø 17, 50 θέσεων, λευκά.
Εγγραφείτε τώρα στο ενημερωτικό μας δελτίο
Θα χρησιμοποιηθεί σύμφωνα με την ιδιωτική μας πολιτική